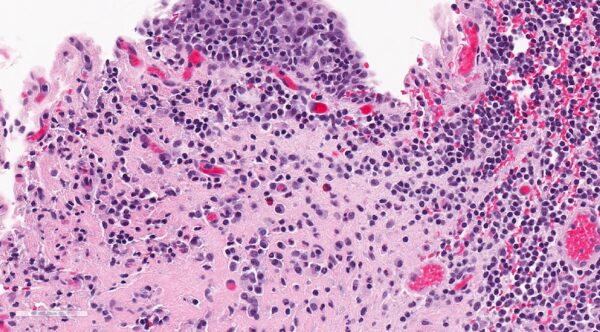
Cistitis intersticial

La cistitis intersticial, también conocida como síndrome de vejiga dolorosa, es una enfermedad compleja caracterizada por dolor durante el llenado de la vejiga, que se alivia al vaciarla. Esta afección suele ir acompañada de urgencia y frecuencia urinaria, con una exageración dramática de las sensaciones normales de llenado vesical y la necesidad de orinar. Es decir, los pacientes experimentan una sensación mucho más intensa de necesidad urgente de orinar y una frecuencia miccional superior a la esperada, lo que altera significativamente su calidad de vida. El dolor es una característica clave de la enfermedad, y su intensidad se ve amplificada debido a la sensibilidad anómala de la vejiga y sus estructuras circundantes.
El diagnóstico de la cistitis intersticial es, en gran medida, un diagnóstico de exclusión. Esto significa que, antes de confirmar la presencia de esta enfermedad, deben descartarse otras posibles causas que puedan provocar síntomas similares. Para poder diagnosticar cistitis intersticial, es esencial que los pacientes tengan cultivos de orina y citologías negativas, lo que asegura que no haya una infección activa en la vejiga. Además, deben descartarse otras condiciones evidentes que puedan generar síntomas semejantes, tales como la cistitis por radiación, la cistitis química (inducida por medicamentos como la ciclofosfamida), infecciones vaginales como la vaginitis, divertículos uretrales o infecciones por herpes genital. La cistitis intersticial debe diagnosticarse solo después de que todas estas posibles causas hayan sido cuidadosamente evaluadas y descartadas.
Es importante señalar que hasta un 40% de los pacientes derivados a urólogos por sospecha de cistitis intersticial terminan siendo diagnosticados con una afección distinta tras una evaluación minuciosa. Este hallazgo subraya la dificultad diagnóstica de la enfermedad y la necesidad de un enfoque exhaustivo en la búsqueda de otras patologías que puedan explicar los síntomas urinarios.
Lo que originalmente se consideraba una enfermedad exclusivamente de la vejiga, centrada en una inflamación o disfunción vesical, ha evolucionado en su conceptualización y, hoy en día, se reconoce como un síndrome de dolor crónico. Esta revalorización de la cistitis intersticial se debe a una mayor comprensión de los mecanismos fisiopatológicos subyacentes. Ya no se considera simplemente una alteración en la vejiga, sino un trastorno que involucra una interacción compleja entre el sistema nervioso, la respuesta inmune y la función de los tejidos vesicales.
La etiología de la cistitis intersticial sigue siendo desconocida, pero es probable que no se trate de una sola enfermedad, sino de varias enfermedades que comparten síntomas similares. Esta diversidad en la presentación clínica sugiere que la cistitis intersticial podría ser el resultado de múltiples factores, que incluyen alteraciones en la barrera epitelial de la vejiga, que podría permitir la filtración de sustancias irritantes hacia las capas más profundas de la mucosa vesical. Este fenómeno aumentaría la sensibilidad y contribuiría a la inflamación, lo que provoca dolor y disfunción urinaria. Además, se ha propuesto que factores neurogénicos, relacionados con anormalidades en el sistema nervioso sensorial, podrían desempeñar un papel crucial en la patogenia de la cistitis intersticial. En este contexto, las alteraciones en la percepción del dolor y en la forma en que el sistema nervioso central procesa las señales provenientes de la vejiga serían fundamentales para comprender la hipersensibilidad que caracteriza a esta enfermedad.
Otra posible causa involucrada en la cistitis intersticial es la autoimmunidad, lo que sugiere que el sistema inmunológico podría atacar erróneamente las células de la vejiga o tejidos circundantes, generando inflamación y daño tisular. Aunque esta teoría aún requiere más investigación, algunos estudios sugieren que las alteraciones en la función del sistema inmunológico podrían estar presentes en muchos pacientes con esta afección.
Además, la cistitis intersticial no suele presentarse de forma aislada, sino que a menudo se asocia con otras enfermedades crónicas, como alergias graves, síndrome del intestino irritable y enfermedades inflamatorias del intestino. Esta comorbilidad podría indicar la presencia de un trastorno sistémico más amplio, en el que la respuesta inflamatoria o la disfunción del sistema nervioso afecten a múltiples órganos y sistemas.
Manifestaciones clínicas
Los síntomas y signos de la cistitis intersticial, o síndrome de vejiga dolorosa, se caracterizan principalmente por la presencia de dolor, presión o incomodidad durante el llenado de la vejiga, que se alivia al vaciarla mediante la micción. Este tipo de dolor es específico y se experimenta a medida que la vejiga se llena con orina, y su intensidad suele disminuir al momento de orinar. Además, los pacientes suelen presentar urgencia urinaria, es decir, una necesidad inmediata de orinar, acompañada de una frecuencia urinaria aumentada, lo que implica la necesidad de orinar con más frecuencia de lo habitual durante el día. La nocturia, que se refiere a la necesidad de orinar durante la noche, es otro síntoma común y puede interrumpir el sueño, afectando la calidad de vida del paciente.
Dado que estos síntomas son similares a los que se presentan en diversas afecciones urológicas, es crucial realizar una evaluación exhaustiva para asegurar que el diagnóstico sea correcto y para excluir otras condiciones que puedan estar provocando un cuadro clínico similar. Es importante que los pacientes sean preguntados sobre su historial de exposición a radioterapia pélvica o tratamientos con ciclofosfamida, ya que estos factores pueden contribuir a la aparición de síntomas que se asemejan a los de la cistitis intersticial. La radioterapia dirigida a la región pélvica y los tratamientos con ciclofosfamida, un agente quimioterapéutico, pueden inducir cambios en la vejiga, como inflamación crónica o daños a los tejidos, que pueden generar síntomas similares.
El examen físico es fundamental para descartar otras causas posibles de los síntomas urinarios. Entre las condiciones que deben ser excluidas se incluyen la infección por herpes genital, que puede causar dolor y molestias en la región genital y en la uretra, y que puede confundirse con cistitis intersticial en su fase aguda. Asimismo, la vaginitis, una inflamación de la vagina que puede estar causada por infecciones, alteraciones hormonales o reacciones alérgicas, también puede presentar síntomas de dolor pélvico y malestar durante la micción, lo que debe ser considerado en el diagnóstico diferencial. Otro trastorno que debe ser descartado es el divertículo uretral, una condición en la que se forma una bolsa en la uretra que puede retener orina y causar síntomas de presión, dolor y dificultades para orinar.
Es crucial realizar una evaluación clínica detallada para identificar adecuadamente la causa subyacente de los síntomas urinarios, ya que los signos de la cistitis intersticial pueden solaparse con los de otras patologías urológicas
Exámenes diagnósticos
Los hallazgos de laboratorio en la cistitis intersticial son fundamentales para el diagnóstico y para excluir otras posibles causas de los síntomas urinarios. En primer lugar, se realiza un análisis de orina, un cultivo de orina y una citología urinaria con el fin de identificar posibles causas infecciosas o malignas de los síntomas. Sin embargo, en la cistitis intersticial, estos resultados son generalmente normales, ya que la enfermedad no está asociada con infecciones bacterianas ni con alteraciones malignas en la vejiga. La ausencia de hallazgos anormales en estos exámenes es un indicador clave que permite avanzar hacia el diagnóstico de cistitis intersticial tras haber descartado otras patologías.
Las pruebas urodinámicas son útiles en el diagnóstico de la cistitis intersticial para evaluar la sensibilidad de la vejiga y su capacidad de cumplimiento, es decir, la capacidad de la vejiga para expandirse sin aumentar excesivamente la presión intravesical. Estas pruebas permiten detectar posibles inestabilidades del músculo detrusor, que pueden ser responsables de síntomas como urgencia o incontinencia. La cistometría, un componente de las pruebas urodinámicas, puede revelar alteraciones en la capacidad de la vejiga para retener orina o en la percepción de la sensación de llenado, lo que es característico en los pacientes con cistitis intersticial.
La cistoscopia es otra herramienta diagnóstica que puede ser utilizada para examinar directamente el interior de la vejiga y observar signos característicos de la cistitis intersticial. Durante este procedimiento, pueden observarse glomerulaciones, que son hemorragias submucosas en la mucosa vesical. Estas glomerulaciones se pueden visualizar especialmente cuando se realiza una distensión hidrostática de la vejiga, un procedimiento en el que se introduce agua en la vejiga para expandirla y facilitar la visualización de la mucosa. Si bien las glomerulaciones son indicativas de cistitis intersticial, no son siempre presentes en todos los casos, y su ausencia no descarta el diagnóstico.
Además de la visualización directa de la vejiga, también es importante determinar la capacidad total de la vejiga durante la cistoscopia, ya que esta medición ayuda a comprender el grado de distensión que la vejiga puede soportar sin causar dolor o incomodidad excesiva. En algunos casos, la capacidad de la vejiga puede estar reducida, lo que se asocia con la hipersensibilidad característica de la enfermedad.
Si se observan lesiones sospechosas durante la cistoscopia, como áreas de sangrado o tumores, se debe realizar una biopsia para excluir otras posibles causas de los síntomas, como carcinoma de vejiga, cistitis eosinofílica o cistitis tuberculosa. Estas condiciones pueden presentar signos clínicos similares a los de la cistitis intersticial, pero requieren tratamiento específico y tienen implicaciones pronósticas diferentes.
En cuanto a la presencia de células mastocíticas submucosas, aunque se ha observado que los mastocitos pueden estar involucrados en la inflamación crónica de la vejiga, su presencia no es un requisito diagnóstico para la cistitis intersticial. El diagnóstico se basa en la exclusión de otras causas y en la identificación de los síntomas característicos, como el dolor al llenar la vejiga y la mejoría al vaciarla.
Diagnóstico diferencial
El diagnóstico diferencial de la cistitis intersticial es un proceso esencial para excluir otras condiciones urológicas y ginecológicas que puedan presentar síntomas similares, como dolor pélvico, urgencia urinaria y frecuencia. Este proceso de exclusión es fundamental para garantizar un diagnóstico preciso y un tratamiento adecuado, dado que la cistitis intersticial no tiene marcadores específicos en las pruebas de laboratorio.
Una de las primeras consideraciones en el diagnóstico diferencial es la historia clínica del paciente, ya que ciertos antecedentes pueden indicar exposiciones previas que podrían haber contribuido al desarrollo de los síntomas. En particular, la exposición a radiación pélvica o el tratamiento con ciclofosfamida (un agente quimioterapéutico) son factores que deben ser investigados. La radioterapia dirigida a la pelvis puede provocar cambios crónicos en la vejiga, incluidos daños a la mucosa y a los músculos de la vejiga, lo que a menudo lleva a síntomas similares a los de la cistitis intersticial. De manera similar, el uso de ciclofosfamida, que puede inducir una forma de cistitis química, puede generar inflamación y daño en los tejidos vesicales. Estas exposiciones deben ser identificadas en la historia clínica, ya que proporcionan pistas importantes para el diagnóstico.
En cuanto a las causas infecciosas, la cistitis bacteriana, el herpes genital y la vaginitis deben ser consideradas y descartadas de forma sistemática, ya que todas ellas pueden causar dolor pélvico y síntomas urinarios similares. El análisis de orina, el cultivo de orina y la citología son pruebas clave para excluir infecciones bacterianas, las cuales se manifestarían con un aumento de leucocitos y bacterias en la orina, así como un cultivo positivo. En el caso de infecciones por herpes genital, que pueden causar dolor y ardor en la región genital y uretral, la observación de lesiones cutáneas o úlceras en la zona genital, junto con la confirmación mediante pruebas específicas, permite realizar un diagnóstico diferencial. La vaginitis, que se refiere a la inflamación de la vagina, puede ser causada por infecciones bacterianas, fúngicas o reacciones alérgicas, y se caracteriza por secreción vaginal, ardor y molestias, lo que se diferencia de la cistitis intersticial mediante la exploración física y los análisis de laboratorio, como los cultivos vaginales.
Otro diagnóstico que debe ser considerado es el de un divertículo uretral, una anomalía estructural que se caracteriza por la formación de una bolsa o saculación en la uretra. Esta condición puede ser sospechada si durante la palpación de la uretra se encuentra una masa endurecida que, al ser presionada, libera pus a través del meato uretral. La presencia de pus es un hallazgo clave, ya que sugiere una infección o inflamación localizada en la uretra, que podría estar originada en el divertículo. Si se sospecha un divertículo uretral, es necesario realizar estudios de imagen, como una cistografía o una ecografía, para confirmar la presencia de esta anomalía.
Por otro lado, el carcinoma uretral también debe ser considerado dentro del diagnóstico diferencial, aunque es mucho menos frecuente. El carcinoma uretral se presenta típicamente como una masa firme palpable durante el examen físico, lo que permite diferenciarlo de otras condiciones no malignas. La palpación de una masa firme y no móvil en la uretra o en las cercanías de la vejiga, junto con la presencia de síntomas como hematuria (sangre en la orina) y dificultad para orinar, sugiere la posibilidad de un tumor uretral. En este caso, se deben realizar pruebas diagnósticas más específicas, como una cistoscopia y biopsia, para confirmar el diagnóstico de malignidad.
Tratamiento
Aunque no existe una cura definitiva para esta enfermedad, muchos pacientes logran un alivio sintomático mediante una variedad de enfoques terapéuticos.
Uno de los procedimientos utilizados en el tratamiento de la cistitis intersticial es la hidrodistensión. Esta técnica consiste en llenar la vejiga con fluido mientras el paciente está bajo anestesia, permitiendo que la vejiga se estire. El objetivo es aliviar la presión y los síntomas asociados con la enfermedad. Aproximadamente entre el 20% y el 30% de los pacientes experimentan una mejora en los síntomas que puede durar entre tres y seis meses. Sin embargo, no todos los pacientes responden de manera favorable a esta intervención.
En cuanto a los tratamientos médicos, uno de los fármacos más utilizados como terapia inicial es la amitriptilina. Este medicamento, un antidepresivo tricíclico, se administra generalmente en dosis que varían entre los 10 y los 75 mg por día de forma oral. Su efectividad en la cistitis intersticial se debe a su capacidad para influir en mecanismos tanto centrales como periféricos. En el sistema nervioso central, la amitriptilina modula la percepción del dolor, mientras que a nivel periférico puede ayudar a relajar los músculos de la vejiga y reducir la inflamación local.
Otro tratamiento utilizado es el nifedipino, un bloqueador de los canales de calcio que se administra en dosis que oscilan entre los 30 y los 60 mg al día de forma oral. Los bloqueadores de los canales de calcio, como el nifedipino, han mostrado cierta actividad en el tratamiento de la cistitis intersticial, ya que actúan disminuyendo la contractilidad de la vejiga y reduciendo la inflamación, aunque su eficacia no es tan pronunciada como la de la amitriptilina.
El pentosano polisulfato sódico, conocido comercialmente como Elmiron, es otro tratamiento oral que se ha utilizado en la cistitis intersticial. Este medicamento es un polisacárido sulfato sintético que ayuda a restaurar la integridad del epitelio de la vejiga, en particular en un subconjunto de pacientes que muestran respuesta positiva. Los estudios clínicos controlados con placebo han demostrado que Elmiron puede ser eficaz para reducir los síntomas en algunos pacientes.
Además, existen otras opciones terapéuticas que incluyen la instilación intravesical de dimetilsulfóxido (DMSO) y heparina. Estas sustancias se administran directamente en la vejiga a través de un catéter, con el objetivo de reducir la inflamación y aliviar el dolor. Sin embargo, la instilación intravesical de bacilo Calmette-Guérin (BCG), que es utilizada en algunas infecciones de la vejiga, no ha mostrado beneficios en el tratamiento de la cistitis intersticial.
En pacientes con una capacidad de vejiga muy reducida (menos de 200 mL), las terapias médicas suelen ser menos efectivas. En estos casos, se puede explorar una variedad de enfoques adicionales, como la estimulación eléctrica nerviosa transcutánea (TENS), la acupuntura, la reducción del estrés, el ejercicio, el biofeedback, el masaje y la relajación del suelo pélvico. Estas modalidades terapéuticas complementarias pueden ayudar a mejorar la calidad de vida de los pacientes al reducir el estrés y promover la relajación muscular en la región pélvica.
En cuanto a las opciones quirúrgicas, estas deben considerarse solo como último recurso. Si los tratamientos convencionales no brindan un alivio adecuado, algunos pacientes pueden requerir una cistectomía uretral, que es una cirugía que implica la extirpación de la vejiga y la creación de una derivación urinaria. Esta intervención se reserva generalmente para los casos más graves de cistitis intersticial, en los que la función de la vejiga está severamente comprometida y no existen otras alternativas terapéuticas viables.

Fuente y lecturas recomendadas:
- Chen PY et al. Comparative safety review of current pharmacological treatments for interstitial cystitis/bladder pain syndrome. Expert Opin Drug Saf. 2021;20:1049. [PMID: 33944647]
- Chermansky CJ et al. Pharmacologic management of interstitial cystitis/bladder pain syndrome. Urol Clin North Am. 2022;49:273. [PMID: 35428433]
- Colemeadow J et al. Clinical management of bladder pain syndrome/interstitial cystitis: a review on current recommendations and emerging treatment options. Res Rep Urol. 2020;12:331. [PMID: 32904438]
- Lopez SR et al. Current standard of care in treatment of bladder pain syndrome/interstitial cystitis. Ther Adv Urol. 2021;13:17562872211022478. [PMID: 34178118]